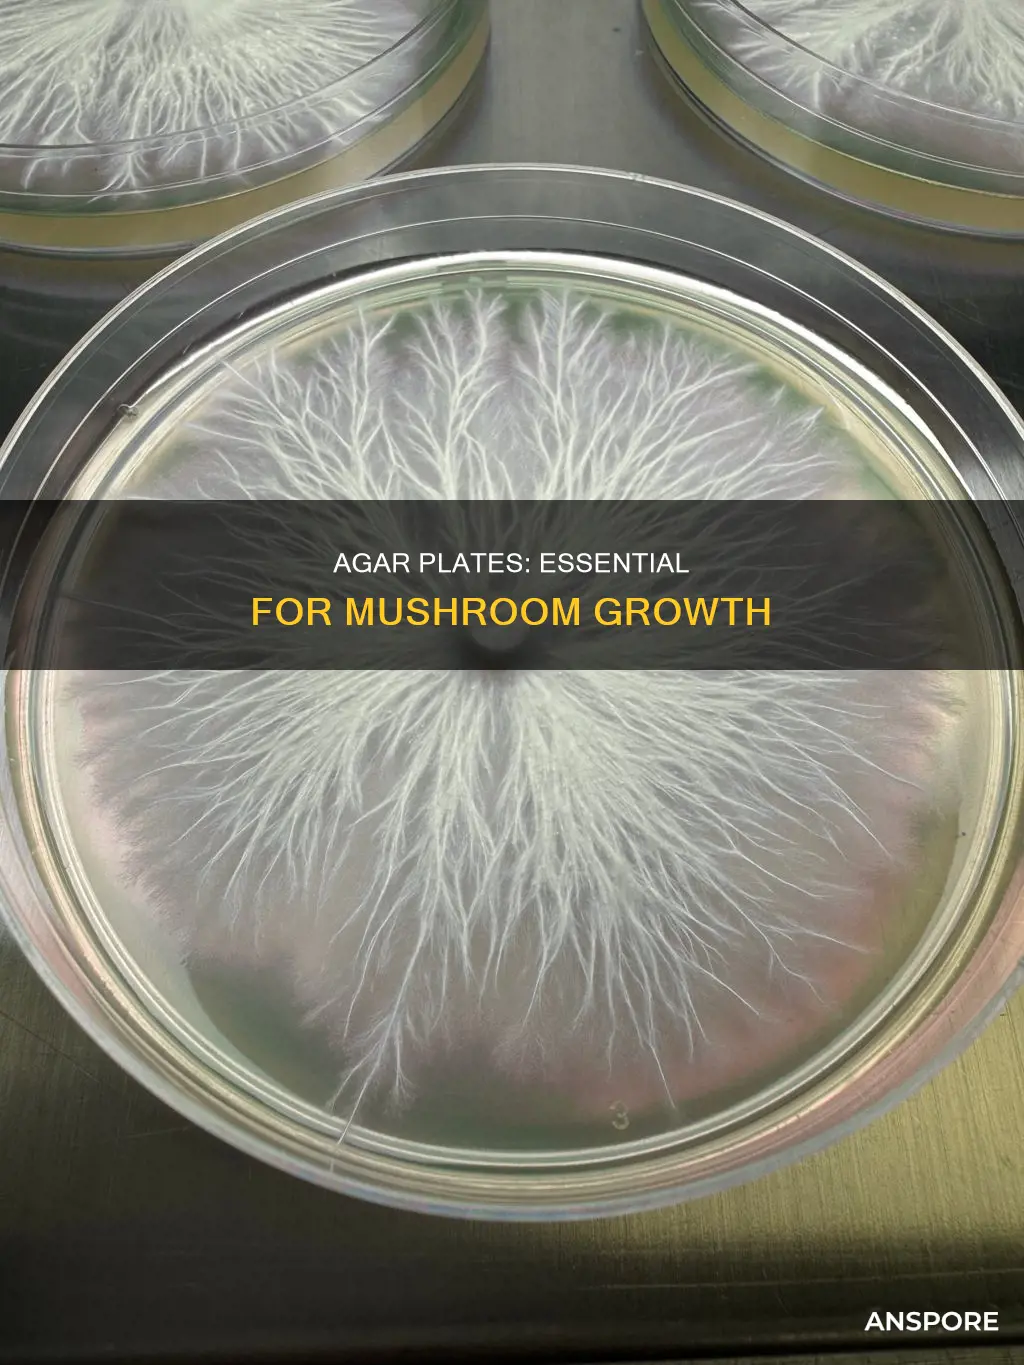
what agar plates for mushrooms

Agar plates are an essential tool in mushroom cultivation, providing a sterile environment for growing and observing the vegetative part of the fungus, known as the mycelium. Agar, derived from seaweed, acts as a food source for the mycelium, facilitating its growth and development. The sterile environment of agar plates prevents contaminants such as bacteria, mould, and other unwanted fungi from invading the culture. This controlled setting allows cultivators to focus on promoting healthy mycelium growth and facilitates the isolation and propagation of robust strains. Agar plates are also valuable for long-term storage, enabling cultivators to maintain pure mushroom cultures and clone desired strains. The ability to maintain sterility, isolate strains, and ensure healthy growth makes agar plates a fundamental tool in successful mushroom cultivation.
| Characteristics | Values |
|---|---|
| Purpose | Agar plates provide a controlled, sterile environment for growing and observing mushroom mycelium, the vegetative part of the fungus. |
| Benefits | Agar plates allow cultivators to isolate and propagate healthy strains, monitor mycelium growth, and prevent contaminants such as bacteria, mould, and other unwanted fungi from invading the culture. |
| Agar Types | Malt Extract Agar (MEA), Potato Dextrose Agar (PDA), Yeast Extract Agar (YEA) |
| MEA Ingredients | Per 500ml of clean water: 10g Agar, 10g Light Malt Extract, and optionally 1g Brewer's Yeast |
| Preparation | Mix dry ingredients with hot water, pour into a glass bottle, and pressure cook for 45 minutes at 15psi. Allow to cool and set, then wrap with parafilm. Store at room temperature initially to check for contamination before moving to the fridge. |
| Long-Term Storage | Transfer a sample of mycelium on agar to a culture slant. Incubate at 75-80°F (24-27°C) in a sealed, clean container. |
| Contamination | If contamination occurs, cut out a piece of healthy mycelium and transfer it to a new sterile agar plate. |
Explore related products
What You'll Learn
- Agar plates provide a sterile environment for mushroom growth
- Agar is a gelatinous substance derived from seaweed
- Agar plates are used to isolate and clone strong mycelium strains
- Agar plates can be used for long-term storage of mycelium
- Different types of agar are used for different purposes in mushroom cultivation

Agar plates provide a sterile environment for mushroom growth
Agar plates are an essential tool in mushroom cultivation, providing a sterile and controlled environment for the growth and observation of mushroom mycelium. The agar in the plates, derived from seaweed, acts as a gelatinous substance that solidifies at room temperature, creating a stable and nutrient-rich medium for the fungi to grow.
The process of preparing agar plates involves mixing a nutrient-rich agar solution, pressure sterilizing it, and then pouring the mixture into sterile Petri dishes. The dishes are then sealed to minimize exposure to contaminants. This controlled environment ensures that cultivators can focus on the healthy growth of the mycelium without the constant threat of contamination from bacteria, mould, or other unwanted fungi.
Agar plates offer a clear and transparent medium, making it easy to observe the growth and development of the mycelium. Cultivators can monitor the spread of the mycelium, identify any abnormalities, and make informed decisions about transferring the mycelium or removing contaminants. The sterile environment of agar plates also enables the isolation and propagation of healthy strains, contributing to the efficiency and success rate of mushroom cultivation.
Additionally, agar plates facilitate the long-term storage of mushroom cultures. By inoculating agar plates with a liquid syringe, cultivators can store cultures for extended periods, ensuring a consistent supply of mushrooms. Agar plates are also valuable for cloning strong mycelium strains, allowing growers to select the most vigorous and productive strains for propagation.
Overall, agar plates play a crucial role in providing a sterile environment for mushroom growth, offering benefits such as controlled conditions, easy observation, contamination prevention, strain isolation, and long-term culture storage. These advantages make agar plates a fundamental tool in the field of mushroom cultivation and microbiology.
The Ultimate Guide to Sautéing Shiitake Mushrooms
You may want to see also

Agar is a gelatinous substance derived from seaweed
Agar is a gelatinous substance derived from red seaweed. It is a plant-based version of gelatin, often used as a solidifying agent in food products. It is also used as a gelling agent, thickener, and stabiliser. In the context of mushroom cultivation, agar is added to a nutrient-rich liquid to create a sterile environment for growing mycelium, the vegetative part of the mushroom.
Agar plates are a fundamental tool in mushroom cultivation and microbiology. They provide a controlled, sterile environment that promotes healthy growth and makes it easier to identify and isolate contaminants. The agar acts as a food source for the mycelium, allowing it to spread and develop. This setup enables cultivators to select and propagate healthy strains, ensuring the best genetics are passed on.
Agar plates are prepared by mixing a nutrient-rich agar solution, pressure sterilising it, and then pouring the mixture into sterile dishes. The most common agar recipe for mushroom cultivation is Malt Extract Agar (MEA), which is rich in nutrients and supports robust mycelial growth. Other recipes include Potato Dextrose Agar (PDA) and Yeast Extract Agar (YEA). The amount of agar added to the mixture determines the firmness of the final product.
Agar plates can be used for various procedures in mushroom cultivation, including growing out spore prints, isolating and cloning strong mycelium strains, and long-term storage of mycelium. They are a valuable tool for maintaining pure mushroom cultures and enhancing the efficiency and success rate of mushroom cultivation.
In summary, agar is a gelatinous substance derived from seaweed that provides a sterile and nutrient-rich environment for mushroom cultivation. Agar plates are an essential tool for growers, offering control, precision, and efficiency in the growing process.
Mushrooms: Fat-Free Superfood?
You may want to see also

Agar plates are used to isolate and clone strong mycelium strains
Agar plates are a foundational tool in mycology and mushroom cultivation, providing a nutrient-rich, sterile medium for fungi to grow. They are particularly valuable for isolating and cloning strong mycelium strains. The agar in the plates acts as a food source for the mycelium, allowing it to spread and develop in a controlled, sterile environment.
To isolate and clone strong mycelium strains, cultivators use a sterile scalpel or inoculation loop to transfer a small piece of healthy mycelium from one plate to another, effectively cloning the strain. This process allows for the selection of the most vigorous and productive mycelium, ensuring that only the best genetics are propagated. Over time, this can lead to more robust mushroom yields and improved strain performance.
Agar plates are also used to store mushroom mycelium for long periods. Once a petri dish is fully colonized, it can be stored in a sealed plastic bag in a refrigerator, and the mycelium can remain viable for up to 12 months or even two years. Proper incubation is critical, providing the ideal environment for the mycelium to grow and colonize the agar surface. The optimal temperature for incubating most types of mushroom mycelium ranges from 75-80°F (24-27°C).
Agar plates provide a clear and transparent medium that makes it easy to observe the growth and development of mycelium. This visibility is essential for monitoring the health and progress of the culture. Cultivators can track how quickly the mycelium spreads, identify any abnormalities, and make informed decisions about when to transfer the mycelium to new plates or substrates.
Where to Buy Frozen Breaded Mushrooms?
You may want to see also
Explore related products

Agar plates can be used for long-term storage of mycelium
Agar plates are an essential tool in mushroom cultivation, providing a sterile environment for growing and observing the vegetative part of the fungus, known as mycelium. The agar in the plates acts as a food source for the mycelium, allowing it to spread and develop in a controlled manner. This setup promotes healthy growth and makes it easier to identify and isolate contaminants.
Agar plates can also be used for long-term storage of mycelium. Once an agar plate has been inoculated with mushroom spores or a mycelium sample, the next critical step is proper incubation. Incubation provides the ideal environment for the mycelium to grow and colonize the agar surface. To achieve this, inoculated agar plates should be placed in a clean, sealable container, such as a plastic tote or a specialized incubator. The optimal temperature for incubating most mushroom mycelium ranges from 75-80°F (24-27°C), which can be maintained using a heating mat, temperature controller, or a warm room. It is important to monitor the plates regularly for signs of mycelial growth and potential contamination.
After the mycelium has fully colonized the agar, it can be transferred to a substrate or directly to a fruiting chamber. However, for long-term storage, the mycelium on agar can be transferred to a culture slant. Culture slants, with their narrow test tube openings, are less prone to contamination and allow for nearly indefinite storage in the refrigerator. This method of long-term storage ensures that healthy and robust mycelium strains can be preserved and utilized in the future, contributing to improved mushroom cultivation outcomes.
The ability to store mycelium for extended periods offers several advantages. Firstly, it enables cultivators to select and preserve the strongest and most productive mycelium strains, ensuring that only the best genetics are propagated. This selective process can lead to more robust mushroom yields and enhanced strain performance over time. Additionally, long-term storage of mycelium allows for flexibility in cultivation schedules, as cultivators can maintain and utilize their strains at their convenience. Proper storage techniques, such as maintaining sterility and preventing contamination, are crucial to the success of long-term mycelium storage in agar plates.
Overall, the use of agar plates for long-term mycelium storage is a valuable technique in mushroom cultivation. It provides a controlled and sterile environment, promotes healthy mycelium growth, facilitates the identification and isolation of contaminants, and enables the preservation of superior strains for future use. By utilizing this method, cultivators can improve their cultivation practices and achieve more successful outcomes in mushroom growing.
Mushroom Festival in Telluride: Date Announcement
You may want to see also

Different types of agar are used for different purposes in mushroom cultivation
Agar plates are a fundamental tool in mushroom cultivation, providing a sterile environment for growing and observing the vegetative part of a mushroom, known as the mycelium. Agar, derived from seaweed, acts as a food source for the mycelium, allowing it to spread and develop in a controlled setting. This setup promotes healthy growth and makes it easier to identify and isolate contaminants.
Malt Extract Agar (MEA)
Malt Extract Agar is one of the most commonly used agars in mushroom cultivation. It is made with nutrient-rich malted barley, providing a similar mix of nutrients to the natural food source of many edible mushrooms. MEA contains various nutrients that support vigorous mycelial growth, making it ideal for cloning mushrooms and creating mushroom cultures. This type of agar is also suitable for growing saprotrophic mushroom species that feed on decaying wood and plant matter. The ingredients for MEA are readily available at most grocery stores or brewers' supply stores.
Potato Dextrose Agar (PDA)
Potato Dextrose Agar is another popular choice for mushroom cultivation. It is made from potatoes and dextrose, providing a nutrient-dense medium that supports a wide range of mushroom species. PDA offers a balanced mix of nutrients that cater to the diverse needs of different mushroom varieties.
Yeast Extract Agar (YEA)
Yeast Extract Agar includes yeast extract, which provides additional nutrients beneficial for certain types of mycelium. The extra nutrients in YEA can promote the growth of specific mushroom species that require a richer food source.
Culture Slant Agar
Culture Slant Agar is used for long-term storage of mushroom cultures. This method involves transferring a sample of mycelium onto an agar plate at an angle, typically in a test tube, allowing for increased surface area. Culture Slant Agar enables mushroom cultivators to maintain pure mushroom cultures over extended periods, ensuring a consistent supply of specific mushroom strains.
General-Purpose Agar
While there are numerous mushroom agar recipes, a general-purpose agar is recommended for beginners. This type of agar allows for basic functions such as germinating spores, isolating mushroom strains, and growing mycelium. It is a good starting point for those new to mushroom cultivation before exploring more complex agar recipes.
The use of specific agar types in mushroom cultivation ensures that the unique nutritional and environmental needs of different mushroom species are met. By selecting the appropriate agar, cultivators can enhance the efficiency and success rate of their mushroom-growing endeavours.
Mushrooms: A Sign of Healthy Soil
You may want to see also
Frequently asked questions
Agar plates are used to grow and observe mycelium, the vegetative part of the mushroom. They also allow cultivators to isolate and propagate healthy strains, monitor mycelium growth, and ensure their cultures remain free from contaminants.
Agar plates provide a sterile environment, preventing contaminants such as bacteria, mould, and other unwanted fungi from invading the culture. Agar plates also allow cultivators to clone strains, maintain and store pure mushroom cultures, and germinate mushroom spores.
There are several types of agar used in mushroom cultivation, each formulated to suit different needs. Some common types include Malt Extract Agar (MEA), Potato Dextrose Agar (PDA), and Yeast Extract Agar (YEA).
Making agar plates can be a challenging task and may require proper equipment. The basic process involves mixing a nutrient-rich agar solution, pressure sterilizing it, and then pouring the mix into sterile Petri dishes. The agar should be allowed to solidify before sealing the dishes to prevent contamination during storage.

























